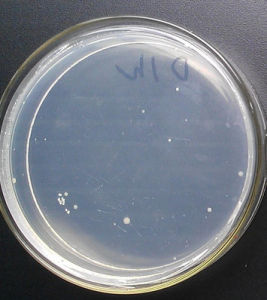
活菌計數

簡介
活菌計數每毫升原菌液活菌數=同一稀釋度三個以上重複平皿
菌落平均數×稀釋倍數×5
此法還可以將稀釋的菌液取0.2m1加到已製備好的平板上,然後用無菌塗棒將菌液塗布整個平板表面,放入適宜溫度下培養,計算菌落數,再按上公式計算出每毫升原菌液的所含活菌總數。
此法可因操作不熟練造成污染,或因培養基溫度過高損傷細胞等原因造成結果不穩定。儘管如此,由於該方法能測出樣品中微量的菌數,仍是教學、科研和生產上常用的一種測定細菌數的有效方法。土壤、水、牛奶、食品和其他材料中所含細菌、酵母、芽抱與抱子等的數量均可用此法測定。但不適於測定樣品中絲狀體微生物,例如放線菌或絲狀真菌或絲狀藍細菌等的營養體等。
除上述兩種常用的計數方法外,還有膜過濾法、比濁法。膜過濾法是當樣品中菌數很低時,可以將一定體積的湖水、海水或飲用水等樣品通過膜過濾器。然後將濾膜乾燥、染色,並經處理使膜透明,再在顯微鏡下計算膜上(或一定面積中)的細菌數;比濁法原理是在一定範圍內,菌的懸液中細胞濃度與混濁度成正比,即與光密度成正比,菌越多,光密度越大。因此可以藉助於分光光度計,在一定波長下,測定菌懸液的光密度,以光密度(O.D.)表示菌量。實驗測量時一定要控制在菌濃度與光密度成正比的線性範圍內,否則不準確。微生物計數法,發展迅速,現有多種多樣的快速、簡易、自動化的儀器和裝置等方法。
相關內容
血球計數法
原理:將1cm2×0.1mm的薄層空間劃分為400小格,從中均勻分布地選取80或100小格,計數其中的細胞數目,換算成單位體積中的細胞數。
適用範圍:個體較大細胞或顆粒,如血球、酵母菌等。不適用於細菌等個體較小的細胞,因為(1)細菌細胞太小,不易沉降;(2)在油鏡下看不清格線線,超出油鏡工作距離。
特點:快速,準確,對酵母菌可同時測定出芽率,或在菌懸液中加入少量美藍可以區分死活細胞
平板活菌計數法
★技術要求:樣品充分混勻,操作熟練快速(15~20min完成操作),嚴格無菌操作;
★注意事項:每一支吸管只能用於一個稀釋度,樣品混勻處理,傾注平板時的培養基溫度;
★適用範圍:中溫、好氧和兼性厭氧、能在營養瓊脂上生長的微生物,
★誤差:多次稀釋造成的誤差是主要來源,其次還有由於樣品內菌體分布不均勻、以及不當操作。